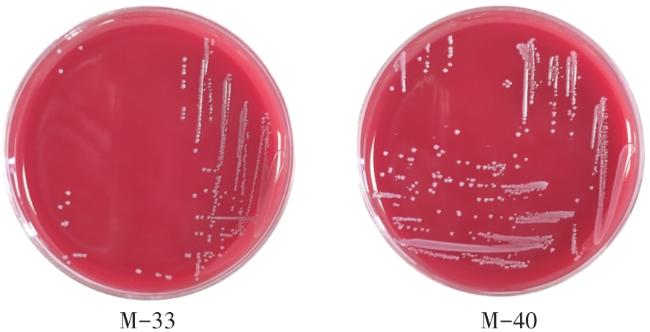

To obtain cat-derived probiotics with probiotic properties and enrich the strain resources of indigenous microecological preparations, this study isolated and identified Lactobacillus strains from cat feces, and determined their antioxidant capacities (including DPPH free radical scavenging rate), as well as probiotic traits such as growth characteristics, carbon source utilization, and hemolysis. A total of 10 strains were obtained from selectively cultured lactic acid bacteria. The DPPH free radical scavenging rates, hydroxyl radical scavenging rates, and reducing capacities of the fermentation supernatant, bacterial suspension, and cell-free lysate of strain M-33 ranged from 102.1% to 107.4%, 72.9% to 84.5%, and 7.8% to 60.6%, respectively; those of strain M-40 ranged from 102.4% to 106.9%, 73.3% to 79.7%, and 0.8% to 16.9%, respectively, indicating strong antioxidant activity in both strains. Colony morphology observation and 16S rDNA identification showed that M-33 and M-40 formed white or milky-white colonies and were Gram-positive; M-33 was short rod-shaped (identified as Lactobacillus reuteri), while M-40 was spherical (identified as Pediococcus acidilactici). In vitro probiotic property evaluation revealed that M-33 grew relatively slower than M-40, with its logarithmic growth phase spanning 2-22 h. Both strains tested positive for cellobiose and maltose, exhibiting broad carbon source utilization. They displayed strong antibacterial activity against Escherichia coli, Salmonella spp., and Staphylococcus aureus but also showed certain drug resistance: M-33 was resistant to ciprofloxacin and erythromycin, while M-40 was only resistant to ciprofloxacin. Neither strain had hemolytic activity. After treatment at 55 °C, their survival rates exceeded 50%; at pH was 2 for 4 h, the survival rates were 54.92% (M-33) and 27.82% (M-40); and with 0.2% bovine bile salt for 4 h, the survival rates reached 71.87% and 70.77%, respectively. Collectively, M-33 and M-40 have robust antioxidant activity, excellent tolerance to high temperature, acid, and bile salt, favorable inhibitory effects on common pathogens, and high safety due to the absence of hemolysis. Thus, they are indigenous probiotics with great potential for development into cat-specific probiotic preparations.